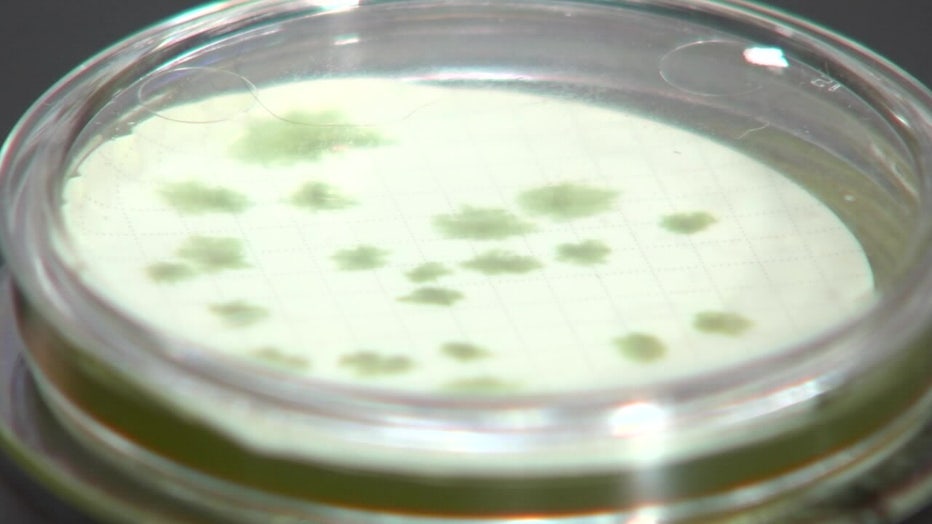

Flesh-eating bacteria may be in Hurricane Idalia flood waters
TAMPA, Fla. - One week after Hurricane Idalia made landfall, medical experts are watching for potential cases of Vibrio vulnificus, bacteria found in brackish waters.
"We are keeping our eyes and ears open to these patients coming to our hospital. And if it's anything like Hurricane Ian, we're likely to see cases popping up here in North Florida coming from these coastal regions," Dr. Norman Beatty, assistant professor of medicine at the University of Florida College of Medicine's Division of Infectious Diseases and Global Medicine, said.
People who waded into Hurricane Idalia floodwaters or walked through their flooded homes to begin cleanup can be at risk for infection from the bacteria that people commonly call "flesh-eating bacteria" if it got into an open wound or cut.
A Petri dish containing Vibrio vulnificus.
"When you get a Vibrio vulnificus skin infection, it is so fast and aggressive. You can put a mark on the edge of (the redness and swelling) with a pen, and an hour or two later, it has gone beyond that mark," stated Dr. Paul Gulig, a professor at the University of Florida College of Medicine’s Department of Molecular Genetics and Microbiology.
RELATED: Florida officials report five deaths from 'flesh-eating' bacteria in Bay Area since January
Although medical experts told FOX 13 they haven’t seen any Idalia-related cases of Vibrio vulnificus yet, 36 cases have already been reported this year across the state, according to the Florida Department of Health numbers.

At least seven Floridians have died from it, including two in Hillsborough and one in Pasco, Polk, and Sarasota Counties.
With Hurricane Ian, 74 cases and 17 deaths were reported.
READ: Hurricane Idalia clean up begins in Bay Area’s hardest hit communities
Last week, the Florida Department of Health warned residents not to wade in standing water before Hurricane Idalia landed.

File: Vibrio vulnificus
"Even as we speak, I've received another consult by a person who has a hand infection that was necrotizing. And I need to see this patient to assess whether they've been close to these storm waters and the brackish water we're discussing," Beatty said.
RELATED: Shore Acres neighborhood accounts for 82% of St. Pete's flood damages from Hurricane Idalia
Since Hurricane Idalia made landfall in a more rural, less-populated area compared to Hurricane Ian, experts are hopeful they will only see a few cases.
But the message to residents remains the same.

Hurricane Idalia flood waters.
"The main thing is, if you have a cut, then don't go in the water in the first place," Gulig said.
One can also contract the bacteria from eating raw oysters.
Those with compromised immune systems are more at risk.


